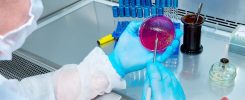

Algumas condições de saúde associadas à demência apareceram precocemente e consistentemente muito antes do diagnóstico, enquanto outras se tornaram significativas muito mais tarde, sugeriu um estudo de coorte publicado na revista Annals of Neurology.
Para pessoas com diagnóstico subsequente de doença de Alzheimer, as associações mais precoces e consistentes em todos os momentos ao longo de um período de 15 anos incluíram depressão, disfunção erétil, anormalidades na marcha, perda auditiva e sintomas nervosos e musculoesqueléticos, relataram Lori Beason-Held, PhD, do National Institute on Aging em Baltimore, e co-autores.
Para aqueles eventualmente diagnosticados com demência vascular, as associações mais precoces e consistentes ao longo de 13 anos foram um eletrocardiograma (ECG) anormal, disritmias cardíacas, doença cerebrovascular, câncer de pele não epitelial, depressão e perda auditiva.
“Embora hipertensão, doença cerebrovascular e depressão sejam mais comumente associadas à demência na literatura, há alguma variabilidade nas condições de saúde ligadas à demência”, escreveram Beason-Held e colegas. “O momento do início dessas condições de saúde também pode ser especialmente importante, mas menos se sabe sobre os anos imediatamente anteriores ao diagnóstico de demência”.
“É fundamental que entendamos a conexão entre a saúde física e cognitiva à medida que nossa população idosa continua a crescer”, acrescentaram os pesquisadores. “Nossos resultados reforçam a necessidade de intervenção médica e tratamento para diminuir o impacto das condições de saúde que ocorrem com a idade, o que poderia reduzir o risco de demência futura em nossos pacientes idosos”.
Os pesquisadores examinaram prontuários médicos para determinar as condições de saúde associadas à demência em intervalos variados antes do diagnóstico de demência em participantes do Estudo Longitudinal de Envelhecimento de Baltimore (BLSA).
Os dados estavam disponíveis para 347 pacientes com doença de Alzheimer (DA), 76 com demência vascular (DV) e 811 participantes de controle sem demência. Regressões logísticas foram realizadas associando códigos de saúde da Classificação Internacional de Doenças, 9ª Revisão (CID-9) com status de demência em todos os momentos, aos 5 e 1 ano(s) antes do diagnóstico de demência e no ano do diagnóstico, controlando para idade, sexo e duração do acompanhamento do prontuário.
Na DA, as associações mais precoces e consistentes em todos os momentos incluíram depressão, disfunção erétil, anormalidades na marcha, perda auditiva e sintomas nervosos e musculoesqueléticos. Cardiomegalia, incontinência urinária, câncer de pele não epitelial e pneumonia não foram significativos até 1 ano antes do diagnóstico de demência.
Na DV, as associações mais precoces e consistentes em todos os momentos incluíram eletrocardiograma (ECG) anormal, disritmias cardíacas, doença cerebrovascular, câncer de pele não epitelial, depressão e perda auditiva. Fibrilação atrial, oclusão de artérias cerebrais, tremor essencial e reflexos anormais não foram significativos até 1 ano antes do diagnóstico de demência.
Esses achados sugerem que algumas condições de saúde estão associadas à demência futura, começando pelo menos 5 anos antes do diagnóstico de demência, e são consistentemente observadas ao longo do tempo, enquanto outras só atingem significância mais perto da data do diagnóstico.
Esses resultados também mostram que existem condições de saúde compartilhadas e distintas associadas à doença de Alzheimer e à demência vascular.
O estudo reforça a necessidade de intervenção e tratamento médico para diminuir o impacto das comorbidades de saúde na população idosa.
Fontes:
ALZHEIMER DEMÊNCIA ESTUDO MEDICINA INTEGRATIVA OTORRINOINTEGRATIVA SAÚDE